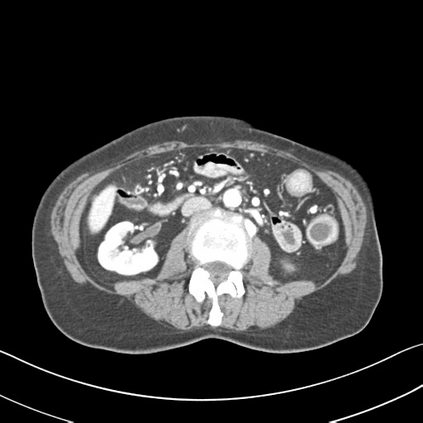

Many techniques have been proposed for image reconstruction in medical imaging that aim to recover high-quality images especially from limited or corrupted measurements. Model-based reconstruction methods have been particularly popular (e.g., in magnetic resonance imaging and tomographic modalities) and exploit models of the imaging system's physics together with statistical models of measurements, noise and often relatively simple object priors or regularizers. For example, sparsity or low-rankness based regularizers have been widely used for image reconstruction from limited data such as in compressed sensing. Learning-based approaches for image reconstruction have garnered much attention in recent years and have shown promise across biomedical imaging applications. These methods include synthesis dictionary learning, sparsifying transform learning, and different forms of deep learning involving complex neural networks. We briefly discuss classical model-based reconstruction methods and then review reconstruction methods at the intersection of model-based and learning-based paradigms in detail. This review includes many recent methods based on unsupervised learning, and supervised learning, as well as a framework to combine multiple types of learned models together.
翻译:提出了许多技术,用于医疗成像图象的图像重建,目的是恢复高质量图像,特别是从有限或腐败的测量中恢复高品质图像,基于模型的重建方法特别受欢迎(例如磁共振成像和摄影模式),利用成像系统物理学模型以及测量、噪音和往往相对简单的物体前置或规范的统计模型,例如,从压缩感等有限数据中广泛利用以偏狭或低级别为基础的正规化者来重建图像,近年来,基于学习的图像重建方法已引起许多注意,并显示出各种生物医学成像应用的希望,这些方法包括综合词典学习、抽筋改造学习和涉及复杂神经网络的不同深度学习形式。我们简要讨论基于模型的典型重建方法,然后详细审查在基于模型和基于学习的范式交汇处的重建方法。本审查包括许多基于非超强学习、监督学习的近期方法,以及将多种学习模式结合起来的框架。